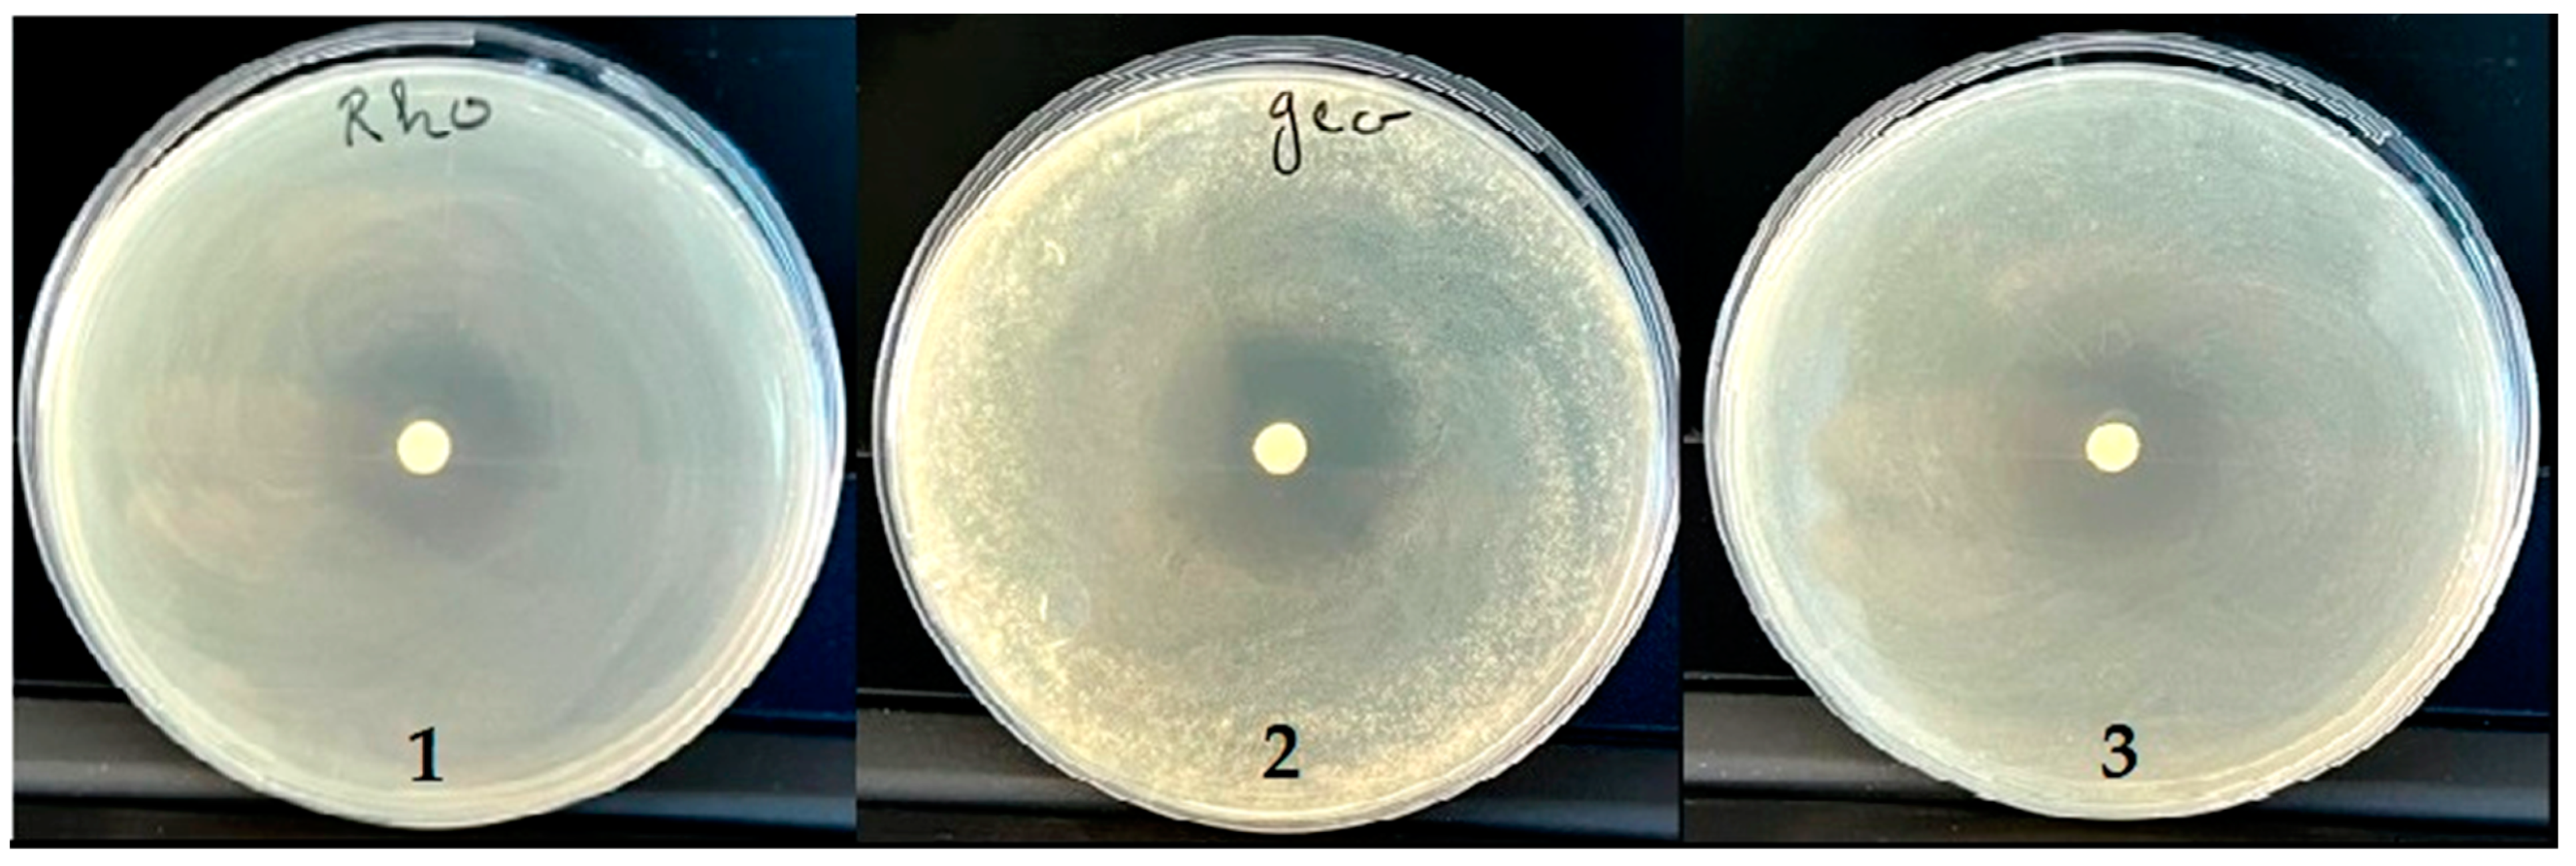
Antibiotics 12 00655 g006

Assessment of the Antioxidant and Antimicrobial Potential of Ptychotis verticillata Duby Essential Oil from Eastern Morocco: An In Vitro and In Silico Analysis
Abstract
1. Introduction
2. Results and Discussion
2.1. Composition of the Essential Oil PVEO
2.2. PASS and ADME Prediction
2.3. Toxicity Prediction Results
2.4. In Silico Prediction of the Tested Biological Activities
2.5. Antioxidant Activity
2.6. Antibacterial Activity
Minimum Inhibitory Concentration (MIC) and Bactericidal Concentration (MBC)
2.7. Antifungal Activity
Minimum Inhibitory Concentration (MIC) and Fungicide (MFC)
3. Materials and Methods
3.1. Plant Material
3.2. Essential Oil Extraction
3.3. Qualitative and Semi-Quantitative Analysis of the PVEO by GC/MS
3.4. PASS, ADME, the Prediction of the Toxicity Analysis (Pro-Tox II)
3.5. Molecular Docking Protocol
3.6. Antioxidant Activity
3.6.1. 2,2-Diphenyl-1-Picrylhydrazyl (DPPH) Scavenging Assay
3.6.2. Ferric-Reducing Antioxidant Power (FRAP)
3.7. Antimicrobial Activity
3.7.1. Bacterial Strains and Growth Conditions
3.7.2. Disc Diffusion Method
3.7.3. Determination of the MIC and the MBC
3.8. Antifungal Activity
3.8.1. Choice and Origin of Strains
3.8.2. Preparation of the Inoculum and Disc Diffusion Method
3.8.3. Determination of the MIC and the MFC
4. Conclusions
Supplementary Materials
Author Contributions
Funding
Institutional Review Board Statement
Informed Consent Statement
Data Availability Statement
Conflicts of Interest
References
- Safari, M.; Ahmady-Asbchin, S. Evaluation of Antioxidant and Antibacterial Activities of Methanolic Extract of Medlar (Mespilus germanica L.) Leaves. Biotechnol. Biotechnol. Equip. 2019, 33, 372–378. [Google Scholar] [CrossRef]
- Dhingra, S.; Rahman, N.A.A.; Peile, E.; Rahman, M.; Sartelli, M.; Hassali, M.A.; Islam, T.; Islam, S.; Haque, M. Microbial Resistance Movements: An Overview of Global Public Health Threats Posed by Antimicrobial Resistance, and How Best to Counter. Front. Public Health 2020, 8, 535668. [Google Scholar] [CrossRef]
- Banu, G.S.; Kumar, G. In-Vitro Antibacterial Activity of Flower Extracts of Woodfordia Fruticosa Kurz. Int. J. Curr. Res. Chem. Pharma. Sci. 2014, 1, 127–130. [Google Scholar]
- Mickymaray, S.; Alturaiki, W. Antifungal Efficacy of Marine Macroalgae against Fungal Isolates from Bronchial Asthmatic Cases. Molecules 2018, 23, 3032. [Google Scholar] [CrossRef] [PubMed]
- Portillo, A.; Vila, R.; Freixa, B.; Adzet, T.; Cañigueral, S. Antifungal Activity of Paraguayan Plants Used in Traditional Medicine. J. Ethnopharmacol. 2001, 76, 93–98. [Google Scholar] [CrossRef]
- Farhadi, F.; Khameneh, B.; Iranshahi, M.; Iranshahy, M. Antibacterial Activity of Flavonoids and Their Structure–Activity Relationship: An Update Review. Phyther. Res. 2019, 33, 13–40. [Google Scholar] [CrossRef]
- Marianne Frieri, K.K.; Boutin, A. Antibiotic Resistance. J Infect. Public Health 2017, 10, 369–378. [Google Scholar] [CrossRef] [PubMed]
- Raunsai, M.; Wulansari, D.; Fathoni, A.; Agusta, A. Antibacterial and Antioxidant Activities of Endophytic Fungi Extracts of Medicinal Plants from Central Sulawesi. J. Appl. Pharm. Sci. 2018, 8, 69–74. [Google Scholar]
- Chandra, H.; Kumari, P.; Yadav, S. Evaluation of Aflatoxin Contamination in Crude Medicinal Plants Used for the Preparation of Herbal Medicine. Orient. Pharm. Exp. Med. 2019, 19, 137–143. [Google Scholar] [CrossRef]
- Chandra, H.; Kumari, P.; Prasad, R.; Gupta, S.C.; Yadav, S. Antioxidant and Antimicrobial Activity Displayed by a Fungal Endophyte Alternaria Alternata Isolated from Picrorhiza Kurroa from Garhwal Himalayas, India. Biocatal. Agric. Biotechnol. 2021, 33, 101955. [Google Scholar] [CrossRef]
- Johnson, O.O.; Ayoola, G.A. Antioxidant Activity among Selected Medicinal Plants Combinations (Multi-Component Herbal Preparation). Int. J. Res. Health Sci. 2015, 3, 526–532. [Google Scholar]
- Bereksi, M.S.; Hassaïne, H.; Bekhechi, C.; Abdelouahid, D.E. Evaluation of Antibacterial Activity of Some Medicinal Plants Extracts Commonly Used in Algerian Traditional Medicine against Some Pathogenic Bacteria. Pharmacogn. J. 2018, 10, 507–512. [Google Scholar] [CrossRef]
- Angane, M.; Swift, S.; Huang, K.; Butts, C.A.; Quek, S.Y. Essential Oils and Their Major Components: An Updated Review on Antimicrobial Activities, Mechanism of Action and Their Potential Application in the Food Industry. Foods 2022, 11, 464. [Google Scholar] [CrossRef]
- Hyldgaard, M.; Mygind, T.; Meyer, R.L. Essential Oils in Food Preservation: Mode of Action, Synergies, and Interactions with Food Matrix Components. Front. Microbiol. 2012, 3, 12. [Google Scholar] [CrossRef] [PubMed]
- Bencheikh, N.; Elbouzidi, A.; Kharchoufa, L.; Ouassou, H.; Alami Merrouni, I.; Mechchate, H.; Es-Safi, I.; Hano, C.; Addi, M.; Bouhrim, M. Inventory of Medicinal Plants Used Traditionally to Manage Kidney Diseases in North-Eastern Morocco: Ethnobotanical Fieldwork and Pharmacological Evidence. Plants 2021, 10, 1966. [Google Scholar] [CrossRef]
- Bnouham, M.; Benalla, W.; Asehraou, A.; Berrabah, M. Antibacterial Activity of Essential Oil from Ptychotis Verticillata. Spat. DD 2012, 2, 69–73. [Google Scholar] [CrossRef]
- Tomi, P.; Bouyanzer, A.; Hammouti, B.; Desjobert, J.-M.; Costa, J.; Paolini, J. Chemical Composition and Antioxidant Activity of Essential Oils and Solvent Extracts of Ptychotis Verticillata from Morocco. Food Chem. Toxicol. 2011, 49, 533–536. [Google Scholar]
- Hayani, M.; Bencheikh, N.; Ailli, A.; Bouhrim, M.; Elbouzidi, A.; Ouassou, H.; Kharchoufa, L.; Baraich, A.; Atbir, A.; Ayyad, F.Z.; et al. Quality Control, Phytochemical Profile, and Antibacterial Effect of Origanum Compactum Benth. Essential Oil from Morocco. Int. J. Plant Biol. 2022, 13, 546–560. [Google Scholar] [CrossRef]
- Bentahar, B. Evaluation Ethnobotanique Des Potentialités Thérapeutiques de Ptychotisverticillata. Ph.D. Thesis, Faculty of Medicine and Pharmacy in Marrakech, Marrakech, Morocco, 2016. [Google Scholar]
- Tefiani, C.; Riazi, A.; Youcefi, F.; Aazza, S.; Gago, C.; Faleiro, M.L.; Pedro, L.G.; Barroso, J.G.; Figueiredo, A.C.; Megías, C. Ammoides Pusilla (Apiaceae) and Thymus Munbyanus (Lamiaceae) from Algeria Essential Oils: Chemical Composition, Antimicrobial, Antioxidant and Antiproliferative Activities. J. Essent. Oil Res. 2015, 27, 131–139. [Google Scholar] [CrossRef]
- Filimonov, D.A.; Lagunin, A.A.; Gloriozova, T.A.; Rudik, A.V.; Druzhilovskii, D.S.; Pogodin, P.V.; Poroikov, V.V. Prediction of the Biological Activity Spectra of Organic Compounds Using the PASS Online Web Resource. Chem. Heterocycl. Compd. 2014, 50, 444–457. [Google Scholar] [CrossRef]
- Shady, N.H.; Soltane, R.; Maher, S.A.; Saber, E.A.; Elrehany, M.A.; Mostafa, Y.A.; Sayed, A.M.; Abdelmohsen, U.R. Wound Healing and Antioxidant Capabilities of Zizyphus Mauritiana Fruits: In-Vitro, In-Vivo, and Molecular Modeling Study. Plants 2022, 11, 1392. [Google Scholar] [CrossRef]
- Gavaric, N.; Mozina, S.S.; Kladar, N.; Bozin, B. Chemical Profile, Antioxidant and Antibacterial Activity of Thyme and Oregano Essential Oils, Thymol and Carvacrol and Their Possible Synergism. J. Essent. Oil Bear. plants 2015, 18, 1013–1021. [Google Scholar] [CrossRef]
- Zhou, F.; Ji, B.; Zhang, H.; Jiang, H.U.I.; Yang, Z.; Li, J.; Li, J.; Yan, W. The Antibacterial Effect of Cinnamaldehyde, Thymol, Carvacrol and Their Combinations against the Foodborne Pathogen Salmonella Typhimurium. J. Food Saf. 2007, 27, 124–133. [Google Scholar] [CrossRef]
- Mickienė, R.; Maruška, A.-S.; Ragažinskienė, O. In Vitro Evidence of Synergistic-Antagonistic Effect for Monarda didyma L. Secondary Metabolites. In Proceedings of the Science and Practice 2015: 6th International Pharmaceutical Conference, Kaunas, Lithuania, 5–6 November 2015. [Google Scholar]
- Brenes, A.; Roura, E. Essential Oils in Poultry Nutrition: Main Effects and Modes of Action. Anim. Feed Sci. Technol. 2010, 158, 1–14. [Google Scholar] [CrossRef]
- Bojarska, J.; Remko, M.; Breza, M.; Madura, I.D.; Kaczmarek, K.; Zabrocki, J.; Wolf, W.M. A Supramolecular Approach to Structure-Based Design with a Focus on Synthons Hierarchy in Ornithine-Derived Ligands: Review, Synthesis, Experimental and in Silico Studies. Molecules 2020, 25, 1135. [Google Scholar] [CrossRef]
- Pires, D.E.V.; Blundell, T.L.; Ascher, D.B. PkCSM: Predicting Small-Molecule Pharmacokinetic and Toxicity Properties Using Graph-Based Signatures. J. Med. Chem. 2015, 58, 4066–4072. [Google Scholar] [CrossRef]
- Brockmöller, J.; Tzvetkov, M.V. Pharmacogenetics: Data, Concepts and Tools to Improve Drug Discovery and Drug Treatment. Eur. J. Clin. Pharmacol. 2008, 64, 133–157. [Google Scholar] [CrossRef]
- Banerjee, P.; Eckert, A.O.; Schrey, A.K.; Preissner, R. ProTox-II: A Webserver for the Prediction of Toxicity of Chemicals. Nucleic Acids Res. 2018, 46, W257–W263. [Google Scholar] [CrossRef] [PubMed]
- Ripphausen, P.; Nisius, B.; Peltason, L.; Bajorath, J. Quo Vadis, Virtual Screening? A Comprehensive Survey of Prospective Applications. J. Med. Chem. 2010, 53, 8461–8467. [Google Scholar] [CrossRef] [PubMed]
- Stanzione, F.; Giangreco, I.; Cole, J.C. Use of Molecular Docking Computational Tools in Drug Discovery, 1st ed.; Elsevier B.V.: Amsterdam, The Netherlands, 2021; Volume 60, ISBN 9780323850568. [Google Scholar]
- Kuntz, I.D.; Blaney, J.M.; Oatley, S.J.; Langridge, R.; Ferrin, T.E. A Geometric Approach to Macromolecule-Ligand Interactions. J. Mol. Biol. 1982, 161, 269–288. [Google Scholar] [CrossRef]
- Rolta, R.; Salaria, D.; Kumar, V.; Patel, C.N.; Sourirajan, A.; Baumler, D.J.; Dev, K. Molecular Docking Studies of Phytocompounds of Rheum Emodi Wall with Proteins Responsible for Antibiotic Resistance in Bacterial and Fungal Pathogens: In Silico Approach to Enhance the Bio-Availability of Antibiotics. J. Biomol. Struct. Dyn. 2022, 40, 3789–3803. [Google Scholar] [CrossRef] [PubMed]
- Salaria, D.; Rolta, R.; Patel, C.N.; Dev, K.; Sourirajan, A.; Kumar, V. In Vitro and in Silico Analysis of Thymus Serpyllum Essential Oil as Bioactivity Enhancer of Antibacterial and Antifungal Agents. J. Biomol. Struct. Dyn. 2021, 40, 10383–10402. [Google Scholar] [CrossRef] [PubMed]
- Ebrahimipour, S.Y.; Sheikhshoaie, I.; Simpson, J.; Ebrahimnejad, H.; Dusek, M.; Kharazmi, N.; Eigner, V. Antimicrobial Activity of Aroylhydrazone-Based Oxido Vanadium (v) Complexes: In Vitro and In Silico Studies. New J. Chem. 2016, 40, 2401–2412. [Google Scholar] [CrossRef]
- Tittal, R.K.; Yadav, P.; Lal, K.; Kumar, A. Synthesis, Molecular Docking and DFT Studies on Biologically Active 1, 4-Disubstituted-1, 2, 3-Triazole-Semicarbazone Hybrid Molecules. New J. Chem. 2019, 43, 8052–8058. [Google Scholar]
- Trevisan, D.A.C.; da Silva, P.V.; Farias, A.B.P.; Campanerut-Sá, P.A.Z.; Ribeiro, T.; Faria, D.R.; de Mendonça, P.S.B.; de Mello, J.C.P.; Seixas, F.A.V.; Mikcha, J.M.G. Antibacterial Activity of Barbatimão (Stryphnodendron adstringens) against Staphylococcus aureus: In Vitro and in Silico Studies. Lett. Appl. Microbiol. 2020, 71, 259–271. [Google Scholar] [CrossRef]
- Priyadarshi, A.; Kim, E.E.; Hwang, K.Y. Structural Insights into Staphylococcus Aureus Enoyl-ACP Reductase (FabI), in Complex with NADP and Triclosan. Proteins Struct. Funct. Bioinforma. 2010, 78, 480–486. [Google Scholar] [CrossRef]
- Rashdan, H.R.M.; Shehadi, I.A.; Abdelrahman, M.T.; Hemdan, B.A. Antibacterial Activities and Molecular Docking of Novel Sulfone Biscompound Containing Bioactive 1,2,3-Triazole Moiety. Molecules 2021, 26, 4817. [Google Scholar] [CrossRef]
- Yi, L.; Lü, X. New Strategy on Antimicrobial-Resistance: Inhibitors of DNA Replication Enzymes. Curr. Med. Chem. 2019, 26, 1761–1787. [Google Scholar] [CrossRef]
- Janakiramudu, D.B.; Subba Rao, D.; Srikanth, C.; Madhusudhana, S.; Sreenivasa Murthy, P.; Nagalakshmidevamma, M.; Chalapathi, P.V.; Naga Raju, C. Sulfonamides and Carbamates of 3-Fluoro-4-Morpholinoaniline (Linezolid Intermediate): Synthesis, Antimicrobial Activity and Molecular Docking Study. Res. Chem. Intermed. 2018, 44, 469–489. [Google Scholar] [CrossRef]
- Kim, O.K.; Barrett, J.F.; Ohemeng, K. Advances in DNA Gyrase Inhibitors. Expert Opin. Investig. Drugs 2001, 10, 199–212. [Google Scholar] [CrossRef]
- Patil, M.; Poyil, A.N.; Joshi, S.D.; Patil, S.A.; Patil, S.A.; Bugarin, A. Design, Synthesis, and Molecular Docking Study of New Piperazine Derivative as Potential Antimicrobial Agents. Bioorg. Chem. 2019, 92, 103217. [Google Scholar] [CrossRef]
- Payne, D.J.; Miller, W.H.; Berry, V.; Brosky, J.; Burgess, W.J.; Chen, E.; DeWolf, W.E., Jr.; Fosberry, A.P.; Greenwood, R.; Head, M.S.; et al. Discovery of a Novel and Potent Class of FabI-Directed Antibacterial Agents. Antimicrob. Agents Chemother. 2002, 46, 3118–3124. [Google Scholar] [CrossRef]
- Kandsi, F.; Elbouzidi, A.; Lafdil, F.Z.; Meskali, N.; Azghar, A.; Addi, M.; Hano, C.; Maleb, A.; Gseyra, N. Antibacterial and Antioxidant Activity of Dysphania ambrosioides (L.) Mosyakin and Clemants Essential Oils: Experimental and Computational Approaches. Antibiotics 2022, 11, 482. [Google Scholar] [CrossRef]
- Sweilam, S.H.; Abdel Bar, F.M.; Foudah, A.I.; Alqarni, M.H.; Elattal, N.A.; El-Gindi, O.D.; El-Sherei, M.M.; Abdel-Sattar, E. Phytochemical, Antimicrobial, Antioxidant, and In Vitro Cytotoxicity Evaluation of Echinops Erinaceus Kit Tan. Separations 2022, 9, 447. [Google Scholar] [CrossRef]
- Heath, R.J.; Rock, C.O. Enoyl-Acyl Carrier Protein Reductase (FabI) Plays a Determinant Role in Completing Cycles of Fatty Acid Elongation in Escherichia coli. J. Biol. Chem. 1995, 270, 26538–26542. [Google Scholar] [CrossRef]
- Kalamorz, F.; Reichenbach, B.; März, W.; Rak, B.; Görke, B. Feedback Control of Glucosamine-6-phosphate Synthase GlmS Expression Depends on the Small RNA GlmZ and Involves the Novel Protein YhbJ in Escherichia coli. Mol. Microbiol. 2007, 65, 1518–1533. [Google Scholar] [CrossRef]
- Milewski, S. Glucosamine-6-Phosphate Synthase—The Multi-Facets Enzyme. Biochim. Biophys. Acta (BBA)-Protein Struct. Mol. Enzymol. 2002, 1597, 173–192. [Google Scholar] [CrossRef]
- Lešnik, S.; Bren, U. Mechanistic Insights into Biological Activities of Polyphenolic Compounds from Rosemary Obtained by Inverse Molecular Docking. Foods 2022, 11, 67. [Google Scholar] [CrossRef]
- Vijesh, A.M.; Isloor, A.M.; Telkar, S.; Arulmoli, T.; Fun, H.-K. Molecular Docking Studies of Some New Imidazole Derivatives for Antimicrobial Properties. Arab. J. Chem. 2013, 6, 197–204. [Google Scholar] [CrossRef]
- Sauvage, E.; Terrak, M. Glycosyltransferases and Transpeptidases/Penicillin-Binding Proteins: Valuable Targets for New Antibacterials. Antibiotics 2016, 5, 12. [Google Scholar] [CrossRef]
- Freischem, S.; Grimm, I.; López-Pérez, A.; Willbold, D.; Klenke, B.; Vuong, C.; Dingley, A.J.; Weiergräber, O.H. Interaction Mode of the Novel Monobactam AIC499 Targeting Penicillin Binding Protein 3 of Gram-Negative Bacteria. Biomolecules 2021, 11, 1057. [Google Scholar] [CrossRef]
- Khoshbakht, T.; Karami, A.; Tahmasebi, A.; Maggi, F. The Variability of Thymol and Carvacrol Contents Reveals the Level of Antibacterial Activity of the Essential Oils from Different Accessions of Oliveria Decumbens. Antibiotics 2020, 9, 409. [Google Scholar] [CrossRef]
- Masoum, S.; Samadi, N.; Mehrara, B.; Mahboubi, M. Potentiality of Independent Component Regression in Assessment of the Peaks Responsible for Antimicrobial Activity of Satureja hortensis L. and Oliveria decumbens Vent. Using GC–MS. J. Iran. Chem. Soc. 2018, 15, 2007–2016. [Google Scholar] [CrossRef]
- Lambert, R.J.W.; Skandamis, P.N.; Coote, P.J.; Nychas, G. A Study of the Minimum Inhibitory Concentration and Mode of Action of Oregano Essential Oil, Thymol and Carvacrol. J. Appl. Microbiol. 2001, 91, 453–462. [Google Scholar] [CrossRef]
- Memar, M.Y.; Raei, P.; Alizadeh, N.; Aghdam, M.A.; Kafil, H.S. Carvacrol and Thymol: Strong Antimicrobial Agents against Resistant Isolates. Rev. Med. Microbiol. 2017, 28, 63–68. [Google Scholar] [CrossRef]
- Trzaskos, J.M.; Fischer, R.T.; Favata, M.F. Mechanistic Studies of Lanosterol C-32 Demethylation. Conditions Which Promote Oxysterol Intermediate Accumulation during the Demethylation Process. J. Biol. Chem. 1986, 261, 16937–16942. [Google Scholar] [CrossRef]
- Sheehan, D.J.; Hitchcock, C.A.; Sibley, C.M. Current and Emerging Azole Antifungal Agents. Clin. Microbiol. Rev. 1999, 12, 40–79. [Google Scholar] [CrossRef]
- Raju, R.V.S.; Datla, R.S.S.; Moyana, T.N.; Kakkar, R.; Carlsen, S.A.; Sharma, R.K. N-Myristoyltransferase. Mol. Cell. Biochem. 2000, 204, 135–155. [Google Scholar] [CrossRef]
- Wright, M.H.; Heal, W.P.; Mann, D.J.; Tate, E.W. Protein Myristoylation in Health and Disease. J. Chem. Biol. 2010, 3, 19–35. [Google Scholar] [CrossRef]
- Spiteller, G. On the Chemistry of Oxidative Stress. J. Lipid Mediat. 1993, 7, 199–221. [Google Scholar]
- Elbouzidi, A.; Ouassou, H.; Aherkou, M.; Kharchoufa, L.; Meskali, N.; Baraich, A.; Mechchate, H.; Bouhrim, M.; Idir, A.; Hano, C.; et al. LC–MS/MS Phytochemical Profiling, Antioxidant Activity, and Cytotoxicity of the Ethanolic Extract of Atriplex halimus L. against Breast Cancer Cell Lines: Computational Studies and Experimental Validation. Pharmaceuticals 2022, 15, 1156. [Google Scholar]
- Rădulescu, M.; Jianu, C.; Lukinich-Gruia, A.T.; Mioc, M.; Mioc, A.; Șoica, C.; Stana, L.G. Chemical Composition, In Vitro and in Silico Antioxidant Potential of Melissa Officinalis Subsp. Officinalis Essential Oil. Antioxidants 2021, 10, 1081. [Google Scholar] [CrossRef]
- Costa, J.D.S.; Ramos, R.D.S.; Costa, K.D.S.L.; Brasil, D.D.S.B.; Silva, C.H.T.D.P.D.; Ferreira, E.F.B.; Borges, R.D.S.; Campos, J.M.; Macêdo, W.J.D.C.; Santos, C.B.R.D. An in Silico Study of the Antioxidant Ability for Two Caffeine Analogs Using Molecular Docking and Quantum Chemical Methods. Molecules 2018, 23, 2801. [Google Scholar] [CrossRef]
- Ouassou, H.; Bouhrim, M.; Kharchoufa, L.; Imtara, H.; elhouda Daoudi, N.; Benoutman, A.; Bencheikh, N.; Ouahhoud, S.; Elbouzidi, A.; Bnouham, M. Caralluma Europaea (Guss) N.E.Br.: A Review on Ethnomedicinal Uses, Phytochemistry, Pharmacological Activities, and Toxicology. J. Ethnopharmacol. 2021, 273, 113769. [Google Scholar] [CrossRef]
- Zeouk, I.; Sifaoui, I.; Jalloul, A.B.; Bekhti, K.; Bazzocchi, I.L.; Piñero, J.E.; Jiménez, I.A.; Lorenzo-Morales, J. Isolation, Identification, and Activity Evaluation of Antioxidant Components from Inula Viscosa: A Bioguided Approach. Bioorg. Chem. 2022, 119, 105551. [Google Scholar] [CrossRef]
- Nafis, A.; Kasrati, A.; Jamali, C.A.; Mezrioui, N.; Setzer, W.; Abbad, A.; Hassani, L. Antioxidant Activity and Evidence for Synergism of Cannabis sativa (L.) Essential Oil with Antimicrobial Standards. Ind. Crops Prod. 2019, 137, 396–400. [Google Scholar] [CrossRef]
- Rossi, P.G.; Berti, L.; Panighi, J.; Luciani, A.; Maury, J.; Muselli, A.; Serra, D.D.R.; Gonny, M.; Bolla, J.-M. Antibacterial Action of Essential Oils from Corsica. J. Essent. Oil Res. 2007, 19, 176–182. [Google Scholar] [CrossRef]
- Ultee, A.; Bennik, M.H.J.; Moezelaar, R. The Phenolic Hydroxyl Group of Carvacrol Is Essential for Action against the Food-Borne Pathogen Bacillus Cereus. Appl. Environ. Microbiol. 2002, 68, 1561–1568. [Google Scholar] [CrossRef]
- Gachkar, L.; Yadegari, D.; Rezaei, M.B.; Taghizadeh, M.; Astaneh, S.A.; Rasooli, I. Chemical and Biological Characteristics of Cuminum Cyminum and Rosmarinus Officinalis Essential Oils. Food Chem. 2007, 102, 898–904. [Google Scholar] [CrossRef]
- Giordani, R.; Kaloustian, J. Action Anticandidosique Des Huiles Essentielles: Leur Utilisation Concomitante Avec Des Médicaments Antifongiques. Phytothérapie 2006, 4, 121–124. [Google Scholar] [CrossRef]
- Slimani, I.; Nassiri, L.; Boukil, A.; Bouiamrine, E.H.; Bachiri, L.; Bammou, M.; Ibijbijen, J. Inventaire Des Plantes Aromatiques et Médicinales Du Site d’intérêt Biologique et Écologique de Jbel Zerhoun, Région Meknès Tafilalet. Afr. Sci. 2016, 12, 393–409. [Google Scholar]
- Alam, A.; Jawaid, T.; Alam, P. In Vitro Antioxidant and Anti-Inflammatory Activities of Green Cardamom Essential Oil and in Silico Molecular Docking of Its Major Bioactives. J. Taibah Univ. Sci. 2021, 15, 757–768. [Google Scholar] [CrossRef]
- Linde, G.A.; Gazim, Z.C.; Cardoso, B.K.; Jorge, L.F.; Tešević, V.; Glamočlija, J.; Soković, M.; Colauto, N.B. Antifungal and Antibacterial Activities of Petroselinum Crispum Essential Oil. Genet. Mol. Res. 2016, 15, gmr.15038538. [Google Scholar] [CrossRef] [PubMed]
- Daina, A.; Michielin, O.; Zoete, V. SwissADME: A Free Web Tool to Evaluate Pharmacokinetics, Drug-Likeness and Medicinal Chemistry Friendliness of Small Molecules. Sci. Rep. 2017, 7, 42717. [Google Scholar] [CrossRef] [PubMed]
- Kandsi, F.; Lafdil, F.Z.; Elbouzidi, A.; Bouknana, S.; Miry, A.; Addi, M.; Conte, R.; Hano, C.; Gseyra, N. Evaluation of Acute and Subacute Toxicity and LC-MS/MS Compositional Alkaloid Determination of the Hydroethanolic Extract of Dysphania ambrosioides (L.) Mosyakin and Clemants Flowers. Toxins 2022, 14, 475. [Google Scholar] [CrossRef]
- Cosconati, S.; Forli, S.; Perryman, A.L.; Harris, R.; Goodsell, D.S.; Olson, A.J. Virtual Screening with AutoDock: Theory and Practice. Expert Opin. Drug Discov. 2010, 5, 597–607. [Google Scholar] [CrossRef]
- Trott, O.; Olson, A.J. AutoDock Vina: Improving the Speed and Accuracy of Docking with a New Scoring Function, Efficient Optimization, and Multithreading. J. Comput. Chem. 2010, 31, 455–461. [Google Scholar] [CrossRef]
- Lountos, G.T.; Jiang, R.; Wellborn, W.B.; Thaler, T.L.; Bommarius, A.S.; Orville, A.M. The Crystal Structure of NAD(P)H Oxidase from Lactobacillus Sanfranciscensis: Insights into the Conversion of O2 into Two Water Molecules by the Flavoenzyme. Biochemistry 2006, 45, 9648–9659. [Google Scholar] [CrossRef]
- Zrouri, H.; Elbouzidi, A.; Bouhrim, M.; Bencheikh, N.; Kharchoufa, L.; Ouahhoud, S.; Ouassou, H.; El Assri, S.; Choukri, M. Phytochemical Analysis, Antioxidant Activity, and Nephroprotective Effect of the Raphanus Sativus Aqueous Extract. Mediterr. J. Chem. 2021, 11, 84. [Google Scholar] [CrossRef]
- Ibrahimi, H.; Hajdari, A. Phenolic and Flavonoid Content, and Antioxidant Activity of Honey from Kosovo. J. Apic. Res. 2020, 59, 452–457. [Google Scholar] [CrossRef]
- Wayne, P.A. Performance Standards for Antimicrobial Susceptibility Testing; National Committee for Clinical Laboratory Standards: Albany, NY, USA, 2002; Volume 12, pp. 1–53. [Google Scholar]
- Remmal, A.; Bouchikhi, T.; Rhayour, K.; Ettayebi, M.; Tantaoui-Elaraki, A. Improved Method for the Determination of Antimicrobial Activity of Essential Oils in Agar Medium. J. Essent. Oil Res. 1993, 5, 179–184. [Google Scholar] [CrossRef]
- Balouiri, M.; Sadiki, M.; Ibnsouda, S.K. Methods for in Vitro Evaluating Antimicrobial Activity: A Review. J. Pharm. Anal. 2016, 6, 71–79. [Google Scholar] [CrossRef] [PubMed]
- Lekbach, Y.; Xu, D.; El Abed, S.; Dong, Y.; Liu, D.; Khan, M.S.; Koraichi, S.I.; Yang, K. Mitigation of Microbiologically Influenced Corrosion of 304L Stainless Steel in the Presence of Pseudomonas Aeruginosa by Cistus Ladanifer Leaves Extract. Int. Biodeterior. Biodegrad. 2018, 133, 159–169. [Google Scholar] [CrossRef]

| Compound Number | Compound Name | Formula | Mol. Wt. | RT (min) | Peak Area (%) |
|---|---|---|---|---|---|
| 1 | α-Thujene | C10H16 | 136.23 | 5.086 | 0.21 |
| 2 | α-Pinene | C10H16 | 136.23 | 5.216 | 0.95 |
| 3 | Sabinene | C10H16 | 136.23 | 5.872 | 0.29 |
| 4 | β-Pinene | C10H16 | 136.23 | 5.945 | 0.16 |
| 5 | β-Myrcene | C10H16 | 136.23 | 6.118 | 0.62 |
| 6 | (+)-4-Carene | C10H16 | 136.23 | 6.593 | 0.48 |
| 7 | m-Cymene | C10H14 | 134.22 | 6.745 | 12.14 |
| 8 | D-Limonene | C10H16 | 136.23 | 6.806 | 22.97 |
| 9 | γ-Terpinene | C10H16 | 136.23 | 7.302 | 15.97 |
| 10 | p-Menth-1-en-4-ol | C10H18O | 154.25 | 9.342 | 0.67 |
| 11 | Thymol | C10H14O | 150.22 | 11.072 | 8.49 |
| 12 | Carvacrol | C10H14O | 150.22 | 11.183 | 37.05 |
| Prediction | 1 | 2 | 3 | 4 | 5 | 6 | 7 | 8 | 9 | 10 | 11 | 12 |
|---|---|---|---|---|---|---|---|---|---|---|---|---|
| PASS Prediction (Pa/Pi) | ||||||||||||
| Antioxidant | n.d. | n.d. | n.d. | n.d. | 0.470/0.008 | n.d. | 0.140/0.115 | 0.157/0.094 | n.d. | 0.151/0.102 | 0.299/0.023 | 0.302/0.023 |
| Antibacterial | 0.166/0.149 | 0.326/0.051 | 0.201/0.117 | 0.233/0.093 | 0.398/0.030 | 0.378/0.036 | 0.213/0.106 | 0.405/0.029 | 0.325/0.051 | 0.328/0.050 | 0.336/0.047 | 0.319/0.053 |
| Antifungal | 0.337/0.067 | 0.439/0.042 | 0.340/0.066 | 0.225/0.121 | 0.584/0.020 | 0.448/0.040 | 0.343/0.065 | 0.582/0.020 | 0.443/0.041 | 0.466/0.036 | 0.464/0.037 | 0.449/0.039 |
| Drug-Likeness Prediction | ||||||||||||
| Lipinski | Yes | Yes | Yes | Yes | Yes | Yes | Yes | Yes | Yes | Yes | Yes | Yes |
| Egan | Yes | Yes | Yes | Yes | Yes | Yes | Yes | Yes | Yes | Yes | Yes | Yes |
| Veber | Yes | Yes | Yes | Yes | Yes | Yes | Yes | Yes | Yes | Yes | Yes | Yes |
| Bioavailability score | 0.55 | 0.55 | 0.55 | 0.55 | 0.55 | 0.55 | 0.55 | 0.55 | 0.55 | 0.55 | 0.55 | 0.55 |
| ADME Prediction Physicochemical Properties | ||||||||||||
| TPSA (Å2) | 0.00 Ų | 0.00 Ų | 0.00 Ų | 0.00 Ų | 0.00 Ų | 0.00 Ų | 0.00 Ų | 0.00 Ų | 0.00 Ų | 20.23 Ų | 20.23 Ų | 20.23 Ų |
| Absorption Parameters | ||||||||||||
| Water Solubility | −4.294 | −3.733 | −4.629 | −4.191 | −4.497 | −3.492 | −4.098 | −3.568 | −3.941 | −2.296 | −2.789 | −2.789 |
| Caco-2 Permeability | 1.386 | 1.38 | 1.404 | 1.385 | 1.400 | 1.392 | 1.526 | 1.401 | 1.414 | 1.502 | 1.606 | 1.606 |
| Intestinal Absorption (%) | 95.25 | 96.04 | 95.35 | 95.52 | 94.69 | 96.30 | 93.64 | 95.89 | 96.21 | 94.01 | 90.84 | 90.84 |
| Solubility Class | Soluble | Soluble | Soluble | Soluble | Soluble | Soluble | Soluble | Soluble | Soluble | Soluble | Soluble | Soluble |
| Distribution Parameters | ||||||||||||
| Log Kp (cm/s) | −5.11 | −3.95 | −4.94 | −4.18 | −4.17 | −4.82 | −3.92 | −3.89 | −3.94 | −4.93 | −4.87 | −4.74 |
| VDss | 0.575 | 0.667 | 0.566 | 0.685 | 0.363 | 0.514 | 0.724 | 0.396 | 0.412 | 0.210 | 0.512 | 0.512 |
| BBB Permeability | Yes | Yes | Yes | Yes | Yes | Yes | Yes | Yes | Yes | Yes | Yes | Yes |
| Metabolism Parameters | ||||||||||||
| CYP2D6 and CYP3A4 Substrate | No | No | No | No | No | No | No | No | No | No | No | No |
| CYP2D6 and CYP3A4 Inhibitors | No | No | No | No | No | No | No | No | No | No | No | No |
| Excretion Parameters | ||||||||||||
| Total Clearance | 0.077 | 0.043 | 0.071 | 0.030 | 0.438 | 0.029 | 0.249 | 0.213 | 0.217 | 1.269 | 0.211 | 0.207 |
| Renal OCT2 Substrate | No | No | No | No | No | No | No | No | No | No | No | No |
| Hepatotoxicity | Carcinogenicity | Cytotoxicity | Immunotoxicity | Mutagenicity | Predicted LD50 (mg/kg) | Class | ||||||
|---|---|---|---|---|---|---|---|---|---|---|---|---|
| Pr | Pb | Pr | Pb | Pr | Pb | Pr | Pb | Pr | Pb | |||
| 1 | Inact. | 0.86 | Inact. | 0.55 | Inact. | 0.98 | Inact. | 0.78 | Inact. | 0.73 | 5000 | V |
| 2 | Inact. | 0.86 | Inact. | 0.60 | Inact. | 0.99 | Inact. | 0.93 | Inact. | 0.75 | 3700 | V |
| 3 | Inact. | 0.81 | Inact. | 0.59 | Inact. | 0.51 | Inact. | 0.82 | Inact. | 0.71 | 5000 | V |
| 4 | Inact. | 0.80 | Inact. | 0.66 | Inact. | 0.97 | Inact. | 0.95 | Inact. | 0.71 | 4700 | V |
| 5 | Inact. | 0.77 | Inact. | 0.60 | Inact. | 0.99 | Inact. | 0.98 | Inact. | 0.75 | 5000 | V |
| 6 | Inact. | 0.86 | Inact. | 0.56 | Inact. | 0.95 | Inact. | 0.72 | Inact. | 0.76 | 4800 | V |
| 7 | Inact. | 0.87 | Act. | 0.67 | Inact. | 0.98 | Inact. | 0.98 | Inact. | 0.89 | 2374 | V |
| 8 | Inact. | 0.76 | Inact. | 0.65 | Inact. | 0.95 | Inact. | 0.97 | Inact. | 0.82 | 4400 | V |
| 9 | Inact. | 0.83 | Inact. | 0.60 | Inact. | 0.98 | Inact. | 0.92 | Inact. | 0.82 | 2500 | V |
| 10 | Inact. | 0.80 | Inact. | 0.72 | Inact. | 0.99 | Inact. | 0.83 | Inact. | 0.88 | 1016 | IV |
| 11 | Inact. | 0.75 | Inact. | 0.60 | Inact. | 0.93 | Inact. | 0.99 | Inact. | 0.89 | 640 | IV |
| 12 | Inact. | 0.75 | Inact. | 0.60 | Inact. | 0.96 | Inact. | 0.99 | Inact. | 0.89 | 810 | IV |
| N° | Compounds | Antibacterial Proteins (PDB IDs) | Antifungal Proteins (PDB IDs) | Antioxidant Proteins (PDB IDs) | |||||||
|---|---|---|---|---|---|---|---|---|---|---|---|
| 1KZN | 3GNS | 2VF5 | 3VSL | 1EA1 | 1IYL | 1N8Q | 1OG5 | 2CDU | 4JK4 | ||
| Free Binding Energy (Kcal/mol) * | |||||||||||
| - | Native Ligand | −9.6 | −6.2 | −7.2 | −7.8 | −5.8 | −5.8 | −6 | −6.6 | −8.6 | −5.3 |
| 1 | α-Thujene | −5.3 | −4.7 | −4.9 | −4.6 | −4.4 | −4.5 | −6.5 | −5.6 | −5.7 | −5.8 |
| 2 | α-Pinene | −4.7 | −5 | −5.2 | −4.7 | −4.2 | −4.9 | −5.6 | −5.6 | −5.5 | −5.9 |
| 3 | Sabinene | −5.5 | −4.7 | −4.8 | −4.7 | −4 | −4.6 | −5.4 | −6.2 | −5.4 | −5.9 |
| 4 | β-Pinene | −4.7 | −4.9 | −5.2 | −4.7 | −4.1 | −4.8 | −5.5 | −5.6 | −5.6 | −5.9 |
| 5 | β-Myrcene | −4.9 | −4.3 | −4.3 | −4.2 | −3.2 | −4.6 | −4.1 | −5.3 | −4.8 | −6.4 |
| 6 | (+)-4-Carene | −5 | −5.1 | −5.1 | −4.8 | −6.1 | −4.8 | −6.1 | −5.8 | −5.8 | −6.2 |
| 7 | m-Cymene | −6 | −4.9 | −5.1 | −4.9 | −4.2 | −4.8 | −4.1 | −5.9 | −5.8 | −7.4 |
| 8 | D-Limonene | −5.8 | −4.7 | −5 | −4.6 | −4.4 | −4.6 | −6 | −6.3 | −5.6 | −6 |
| 9 | γ-Terpinene | −5.8 | −4.7 | −5 | −4.6 | −4.3 | −4.7 | −5.1 | −6.1 | −5.6 | −7 |
| 10 | p-Menth-1-en-4-ol | −6.2 | −5.2 | −5.5 | −5.1 | −4.4 | −4.8 | −5.8 | −5.9 | −5.7 | −6.2 |
| 11 | Thymol | −6.2 | −5.1 | −5.2 | −5.1 | −4.7 | −4.7 | −6.2 | −6 | −5.5 | −6.2 |
| 12 | Carvacrol | −6 | −5.4 | −5.3 | −5.1 | −4.7 | −5.3 | −6.2 | −6.3 | −6 | −6.4 |
| Antioxidant Tests | DPPH Assay | FRAP Test |
|---|---|---|
| Inhibitory Concentration 50 (μg/mL) | ||
| PVEO | 70.6 ± 0.005 | 50 ± 0.001 |
| Ascorbic acid * | 21.06 ± 0.001 | 19.33 ± 0.001 |
| Bacterial Strains | PVEO | Gentamicin (1 mg/mL) | |||
|---|---|---|---|---|---|
| MIC (%) | MBC (%) | MBC/MIC | IZ (mm) | IZ (mm) | |
| L. innocua | 0.5 | 1 | 2 | 23.00 | 21.50 |
| E. coli | 0.25 | 1 | 4 | 46.25 | 22.50 |
| S. aureus | 0.25 | 1 | 4 | 36.50 | 19.50 |
| P. aeruginosa | 0.5 | 1 | 2 | 22.50 | 20.50 |
| Fungal Strains | PVEO | Cycloheximide (1 mg/mL) | |||
|---|---|---|---|---|---|
| MIC (%) | MFC (%) | MFC/MIC | IZ (mm) | IZ (mm) | |
| R. glutinis | 1 | 1 | 1 | 19.50 | 21.00 |
| G. candidum | 1 | 1 | 1 | 31.75 | 23.00 |
| C. albicans | 1 | 1 | 1 | 29.50 | 21.40 |
| Proteins/PDB IDs | Grid Box Size | Gride Box Center | Native Ligand | Reference |
|---|---|---|---|---|
| DNA Gyrase Topoisomerase II (E. coli)/1KZN | size_x = 40 size_y = 40 size_z = 40 | center_x = 19.528 center_y = 19.500 center_z = 43.031 | Clorobiocin | [37] |
| Glucosamine-6-Phosphate Synthase/2VF5 | size_x = 70 size_y = 64 size_z = 56 | center_x = 30.590 center_y = 15.822 center_z = 3.4970 | Glucosamine-6-Phosphate | [36] |
| Enoyl-Acyl Carrier Protein Reductase (S. aureus)/3GNS | size_x = 40 size_y = 40 size_z = 40 | center_x = −14.280 center_y = 0.56200 center_z = −21.462 | Triclosan | [38,39] |
| Penicillin Binding Protein 3/3VSL | size_x = 40 size_y = 40 size_z = 40 | center_x = 18.391 center_y = −48.761 center_z = 23.317 | Cefotaxime | [34,35] |
| Cytochrome P450 14 Alpha-Sterol Demethylase/1EA1 | size_x = 40 size_y = 40 size_z = 40 | center_x = 17.702 center_y = −3.978 center_z = 67.221 | Fluconazole | [34,35] |
| N-Myristoyl Transferase/1IYL | size_x = 40 size_y = 40 size_z = 40 | center_x = −11.256 center_y = 49.991 center_z = 1.040 | Fluconazole | [34,35] |
| Lipoxygenase/1N8Q | size_x = 40 size_y = 40 size_z = 40 | center_x = 22.455 center_y = 1.2930 center_z = 20.362 | Protocatechuic Acid | [65] |
| CYP2C9/1OG5 | size_x = 12.387 size_y = 11.653 size_z = 11.654 | center_x = −19.823 center_y = 86.686 center_z = 38.275 | Warfarin | [65] |
| NADPH Oxidase/2CDU | size_x = 14.007 size_y = 14.997 size_z = 18.795 | center_x = 18.997 center_y = −5.777 center_z = −1.808 | Adenosine-5′-Diphosphate | [65,81] |
Disclaimer/Publisher’s Note: The statements, opinions and data contained in all publications are solely those of the individual author(s) and contributor(s) and not of MDPI and/or the editor(s). MDPI and/or the editor(s) disclaim responsibility for any injury to people or property resulting from any ideas, methods, instructions or products referred to in the content. |
© 2023 by the authors. Licensee MDPI, Basel, Switzerland. This article is an open access article distributed under the terms and conditions of the Creative Commons Attribution (CC BY) license (https://creativecommons.org/licenses/by/4.0/).
Share and Cite
Taibi, M.; Elbouzidi, A.; Ou-Yahia, D.; Dalli, M.; Bellaouchi, R.; Tikent, A.; Roubi, M.; Gseyra, N.; Asehraou, A.; Hano, C.; et al. Assessment of the Antioxidant and Antimicrobial Potential of Ptychotis verticillata Duby Essential Oil from Eastern Morocco: An In Vitro and In Silico Analysis. Antibiotics 2023, 12, 655. https://doi.org/10.3390/antibiotics12040655
Taibi M, Elbouzidi A, Ou-Yahia D, Dalli M, Bellaouchi R, Tikent A, Roubi M, Gseyra N, Asehraou A, Hano C, et al. Assessment of the Antioxidant and Antimicrobial Potential of Ptychotis verticillata Duby Essential Oil from Eastern Morocco: An In Vitro and In Silico Analysis. Antibiotics. 2023; 12(4):655. https://doi.org/10.3390/antibiotics12040655
Chicago/Turabian StyleTaibi, Mohamed, Amine Elbouzidi, Douaae Ou-Yahia, Mohammed Dalli, Reda Bellaouchi, Aziz Tikent, Mohammed Roubi, Nadia Gseyra, Abdeslam Asehraou, Christophe Hano, and et al. 2023. "Assessment of the Antioxidant and Antimicrobial Potential of Ptychotis verticillata Duby Essential Oil from Eastern Morocco: An In Vitro and In Silico Analysis" Antibiotics 12, no. 4: 655. https://doi.org/10.3390/antibiotics12040655
APA StyleTaibi, M., Elbouzidi, A., Ou-Yahia, D., Dalli, M., Bellaouchi, R., Tikent, A., Roubi, M., Gseyra, N., Asehraou, A., Hano, C., Addi, M., El Guerrouj, B., & Chaabane, K. (2023). Assessment of the Antioxidant and Antimicrobial Potential of Ptychotis verticillata Duby Essential Oil from Eastern Morocco: An In Vitro and In Silico Analysis. Antibiotics, 12(4), 655. https://doi.org/10.3390/antibiotics12040655

